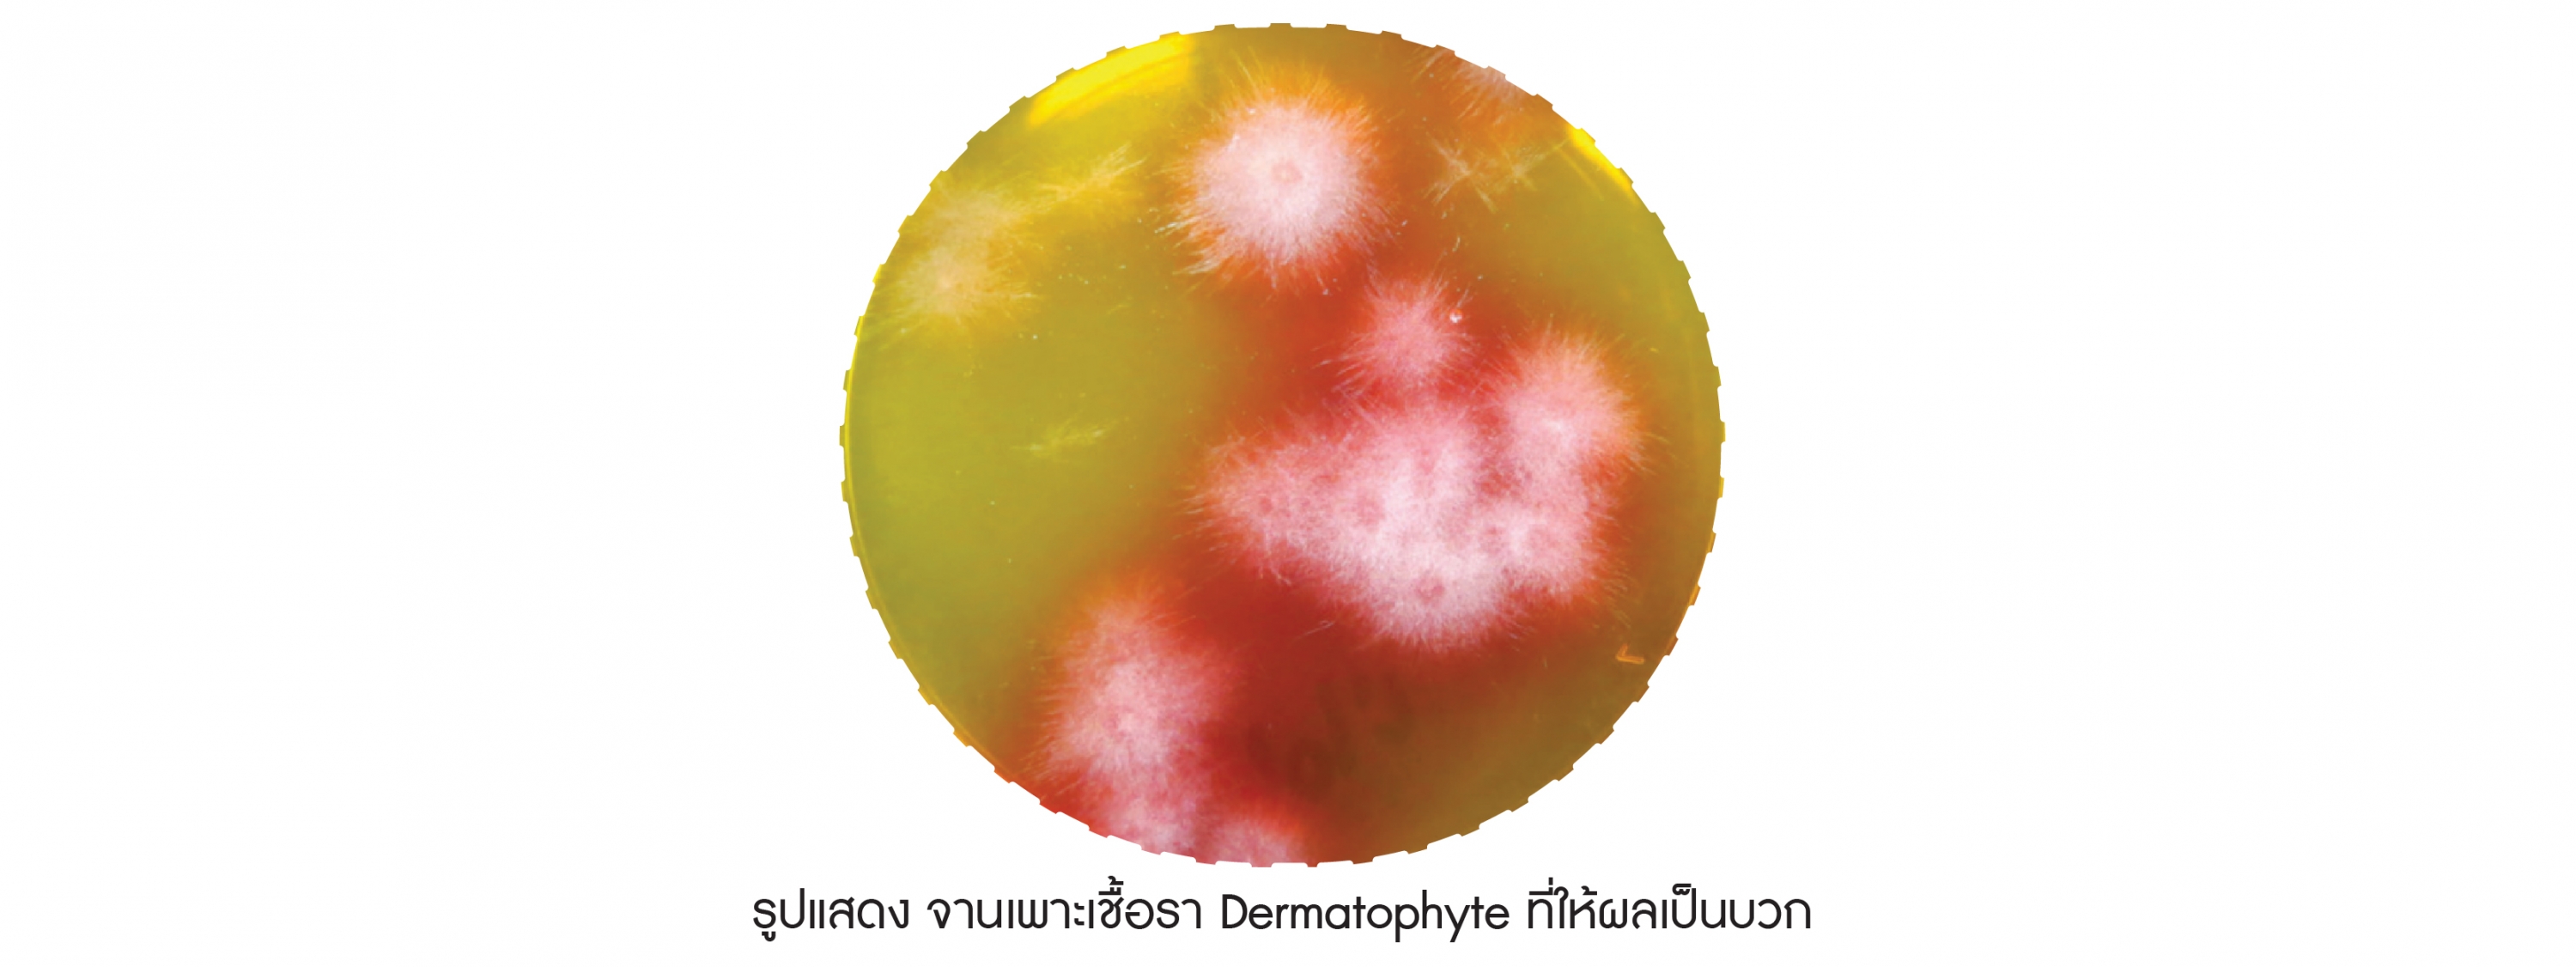

Fact เกี่ยวกับการตรวจวินิจฉัยโรคติดเชื้อรา Dermatophyte
ส่อง Wood’s lamp แล้วไม่เรืองแสง ก็เป็นเชื้อราได้
Dermatophyte ที่พบบ่อยในสุนัขและแมว ได้แก่ Microsporum canis, Trichophyton spp. และ Microsporum gypseum ซึ่งมีเพียง M.canis ที่สามารถตรวจด้วย Wood’s lamp ได้ เนื่องจากเป็นตัวเดียวที่มีการผลิต pteridine ซึ่งสามารถเรืองแสงได้เมื่อส่อง Wood’s lamp ดังนั้นสุนัข หรือแมวที่ติดเชื้อรา M.gypseum, Trichophyton spp. จะไม่พบการเรืองแสงจากการส่อง Wood’s lamp
ส่อง Wood’s lamp แล้วเรืองแสง ก็ไม่เป็นเชื้อราได้เหมือนกัน
บริเวณรอยโรคที่มีสะเก็ดค่อนข้างเยอะ การส่อง Wood’s lamp สามารถเกิด False positive ได้

จานเพาะเชื้อราเปลี่ยนสี แต่อาจจะไม่ใช่ dermatophyte ก็ได้
เชื้อราที่ปนเปื้อนในสิ่งแวดล้อม หากปนเปื้อนไปบนจานเพาะเชื้อจะสามารถเติบโตและเปลี่ยนสี media จากเหลืองเป็นแดงได้เช่นกัน แต่การเปลี่ยนสีของ media จากเชื้อราที่ไม่ใช่ Dermatophyte จะเกิดขึ้นหลังจากเพาะเชื้อ 12 วัน และสีของโคโลนีที่เกิดขึ้นจะเป็นสีเขียว ดำ หรือเทา แต่หากเป็นเชื้อรากลุ่ม Dermatophyte โคโลนีจะเป็นสีขาว และเปลี่ยนสี media หลังเพาะเชื้อ 2 – 12 วัน ดังนั้นจึงต้องตรวจจานเพาะเชื้อราทุกวัน เพื่อป้องกันการแปลผลที่คลาดเคลื่อน
การเพาะเชื้อราสามารถใช้วางแผนการรักษาได้
หลังการกินยารักษาเชื้อรา ควรมีการเพาะเชื้อราซ้ำ เพื่อประเมินผลการรักษา โดยสัตวแพทย์ทางผิวหนังแนะนำว่าควรหยุดยาเมื่อผลเพาะเชื้อราเป็นลบ 2 ครั้ง โดยเพาะเชื้อราห่างกัน 4 สัปดาห์
การตรวจเชื้อรา Dermatophyte ด้วย PCR แม้ผลเป็นบวก แต่สัตว์เลี้ยงอาจไม่ติดเชื้อ
การตรวจด้วยวิธี PCR มี Sensitivity สูง จึงไม่สามารถแยกเชื้อที่ปนเปื้อนบนขน กับสัตว์ที่ติดเชื้อออกจากกันได้ ทำให้สัตว์เลี้ยงที่มีผลบวก อาจไม่ใช่ตัวที่มีการติดเชื้อ แนะนำให้อาบน้ำด้วยแชมพูยาฆ่าเชื้อราก่อนเก็บตัวอย่าง เพื่อลดปริมาณเชื้อที่ปนเปื้อน และเพื่อเพิ่มความแม่นยำในการตรวจ

รอยโรคแปลกๆใช้ Biopsy ช่วยวินิจฉัย
การติดเชื้อรา Dermatophyte ในเคสส่วนใหญ่จะมีรอยโรคที่เป็นเอกลักษณ์ แต่ยังมีอีกหลายเคสที่รอยโรคอาจทำให้สับสนกับโรคอื่นๆ เช่น pustular dermatophytosis ที่รอยโรคจะคล้ายคลึงกับโรค pemphigus, การเกิด kerion ในสัตว์ป่วย หรือการเกิด subcutaneous nodule จากการติดเชื้อ Dermatophyte ในแมวขนยาว จะคล้ายคลึงกับเนื้องอก ดังนั้นการเก็บชื้นเนื้อส่งตรวจสามารถช่วยวินิจฉัยแยกโรคได้ โดยสามารถใช้ Biopsy Punch ในการเก็บชิ้นเนื้อได้ ขนาดที่แนะนำคือ 6 หรือ 8 มิลลิเมตร
..................
Reference :
- Karen M.,2019, Dermatophytosis in cats and dogs: a practical guide to diagnosis and treatment, In Practice May 2019 | Volume 41 | 138-147
- BSAVA Manual of Canine and Feline Dermatology, 4th Edition
..................
บทความโดย
สพ.ญ.อภิลักษณ์ มหัธนันท์
..................
#เครื่องมือสัตวแพทย์ #คลินิกสัตวแพทย์ #โรงพยาบาลสัตว์ #อุปกรณ์สัตว์เลี้ยง #อุปกรณ์สัตวแพทย์ #BEC #becvet #BECpremium #ไหมเย็บ #ไหมเย็บแผลสัตว์เลี้ยง #เชื้อราแมว #เชื้อราสุนัข #เชื้อราในสัตว์เลี้ยง #dermatophytetest #Biopsy Punch
